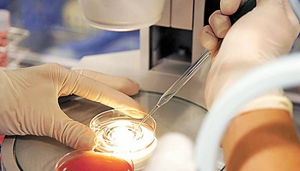

Plano de saúde deve cobrir despesas com fertilização in vitro
A Unimed Planalto Médio, do RS, deve fornecer a uma paciente os meios necessários para a realização de fertilização "in vitro", suportando despesas hospitalares e os materiais para o tratamento. O pedido da mulher foi acolhido em tutela antecipada deferida pela juíza de Direito Lizandra Cericato Villarroel, da 3ª vara Cível da comarca de Passo Fundo/RS.
Diante da dificuldade de engravidar, foi recomendado à paciente o tratamento médico de fertilização. A magistrada entendeu presente a verossimilhança das alegações da parte autora, beneficiária do plano de saúde fornecido pela Unimed, que administrativamente se negou a custear o tratamento indicado.
"O fundado receio de dano irreparável ou de difícil reparação transparece das peculiaridades da condição de saúde da autora, que, diagnosticada com 'quadro de endometriose profunda com infertilidade', apresenta crescente dificuldade de engravidar, sobretudo por já estar com 40 anos, circunstância que faz avultar os riscos à saúde da paciente e do futuro feto".
A decisão também considerou não haver no contrato específica exclusão para o tratamento da fertilização "in vitro", como é possível constatar do item que trata das exclusões e limitações.
Ao admitir a normal delonga no trâmite processual, que poderia acarretar ainda maior risco e perda da chance, por conta da idade da autora, a juíza deferiu a tutela antecipada.
Processo: 1.15.0018295-0
Confira a liminar.